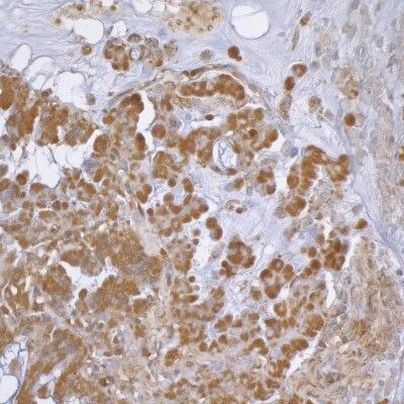
beta Actin Antibody in Immunohistochemistry (Paraffin) (IHC (P))

Search
Invitrogen
beta Actin Polyclonal Antibody
{{$productOrderCtrl.translations['antibody.pdp.commerceCard.promotion.promotions']}}
{{$productOrderCtrl.translations['antibody.pdp.commerceCard.promotion.viewpromo']}}
{{$productOrderCtrl.translations['antibody.pdp.commerceCard.promotion.promocode']}}: {{promo.promoCode}} {{promo.promoTitle}} {{promo.promoDescription}}. {{$productOrderCtrl.translations['antibody.pdp.commerceCard.promotion.learnmore']}}
产品信息
PA1-32416
宿主/亚型
分类
类型
抗原
偶联物
形式
浓度
保存条件
运输条件
RRID
产品详细信息
Store as concentrated solution. Centrifuge briefly prior to opening vial. Store at 4°C. DO NOT FREEZE.
Predicted Reactivity: Chimpanzee, Gorilla, Orangutan, Panda (>80% identity).
靶标信息
Beta actin is one of six actin isoforms which have been identified. Beta actin is a non-muscle cytoskeletal protein in all human cell types and is involved in cell motility, structure, and integrity. There are six different actin isoforms in human. The beta isoform of actin, along with gamma actin, coexist in most cell types as components of the cyto-skeleton. Beta actins are cytoplasmic proteins ubuquitously expressed in all eukaryotic cells. Polymerization of globular actin (G-actin) leads to a structural filament (F-actin) in the form of two stranded helix. Actins are highly conserved proteins that are involved in cell motility, structure and integrity. Because beta actin is ubiquitously expressed in all eukaryotic cells, it is frequently used as a loading control for assays involving protein detection, such as Western blotting. Antibodies to beta-actin provide a specific and useful tool in studying the intracellular distribution of beta-actin and the static and dynamic aspects of the cytoskeleton.
仅用于科研。不用于诊断过程。未经明确授权不得转售。